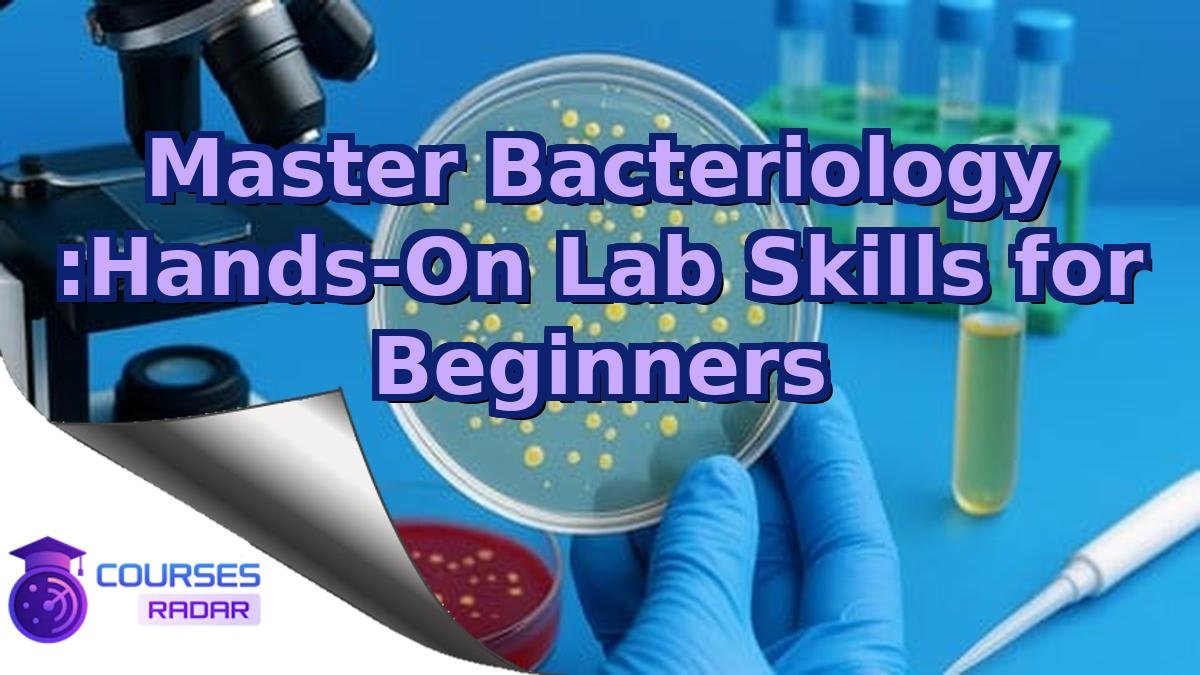
Master Bacteriology :Hands-On Lab Skills for Beginners

this course is designed for learners who want a clear and structured introduction to Master Bacteriology. The lessons follow a calm, step-by-step approach that focuses on the essentials, so you are never overloaded with unnecessary detail. Instead of searching through unconnected videos and articles, you work through a self-paced online training that shows how each idea in builds on the previous one.
This makes it easier to stay focused, revisit important topics when needed, and gradually turn new information into practical skills you can use in real situations.
Overview
The first section of the course gives you a structured entry into the world of Master Bacteriology. It highlights the central principles that shape the broader field of , ensuring that you understand the meaning behind the methods used later in the course.
These explanations help you recognise patterns and make informed decisions as you progress. You begin to see how the different parts of the topic work together, creating a solid base for the lessons that follow.
Who Is This Course For?
this training is aimed at learners who want a clear and structured introduction to Master Bacteriology without needing to work through scattered tutorials. It suits people who prefer calm, step-by-step explanations and who appreciate seeing how ideas build on each other rather than being presented in isolation.
Whether you are restarting your learning journey, adding a new skill to your profile, or simply exploring a topic that interests you, the course assumes no special background knowledge. It is designed to be approachable for motivated beginners as well as for more experienced learners who want to organise what they already know.
What You Will Learn
You will discover the key concepts behind Master Bacteriology, explained through practical examples that reflect typical tasks in . The course focuses on clarity, helping you understand the purpose of each idea rather than just memorizing steps. This approach creates a solid, long-lasting understanding.
Once the training is complete, you will be able to apply the principles of the program independently. You will know how to use the techniques and how to adapt them to new situations.
Requirements
Learners can begin this course with only basic computer familiarity and an interest in exploring Master Bacteriology. No advanced experience is required, as the lessons introduce each concept with clear examples and straightforward language. This makes the material suitable for both beginners and those refreshing their skills.
A standard computer and an internet connection are sufficient to participate. Everything else is explained and demonstrated during the course itself.
Learning Format and Course Structure
This course presents each idea in an organized and easy-to-follow sequence. Lessons highlight key aspects of Master Bacteriology and show how they fit into the broader environment. The straightforward structure helps you stay focused and engaged.
You can complete the training at the pace that suits you best. The layout allows you to revisit earlier lessons or repeat examples whenever you need extra clarity.
Benefits of Taking This Course
The course helps you develop both insight and routine in dealing with Master Bacteriology. The examples and explanations show how the concepts appear in real situations, making the subject in less abstract and more approachable. You become familiar with patterns that you will see again in future work.
Completing this course means you will not only know the theory but also understand how to use it. This mix of knowledge and practice can improve the quality of your decisions and results.
Frequently Asked Questions
1. What makes this course different from random tutorials?
Unlike isolated tutorials, the course offers a continuous, structured path through Master Bacteriology, showing how the pieces fit together in .
2. Can I start the course at any time?
Yes, you can begin whenever it suits you and move through the material according to your own timetable.
3. Is it possible to only study certain parts of the course?
You can focus on the sections that are most relevant to you, but following the full sequence gives you the most coherent understanding.
Summary
The course brings together the main features of Master Bacteriology into a single, coherent learning experience. Instead of dealing with isolated explanations, you see how the concepts interact and why they matter in . This helps turn a complex subject into something more approachable and organised.
With this training completed, you have a reliable base you can use and extend. Whether you continue with related courses, apply the material directly, or simply keep it as a reference, the structure and clarity gained here remain valuable.
If Master Bacteriology is relevant for your current goals, you can learn more about the program on our website. The course page provides an overview of the modules, the learning approach, and simple instructions on how to get started.